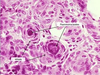

Malignant diseases of the ovary Flashcards
(32 cards)
Summarise the epidemiology of ovarian cancer.
- 1.4% lifetime risk
- 2nd most common gynaelogical cancer
- Mean age at presentation is 64
- Less than 3% occur in <35 year olds
What are the 3 types of primary ovarian timours?
- Epithelial cell (80-90% of ovarian tumours)
- Sex Cord Stromal cell
- Germ Cell (10%)
What is the name for secondary ovarian tumour, i.e. from metastatic spread?
On histology, what cell type defines this tumour?
Krukenberg tumour. They clasically arise from GI tract (colon, stomach) and the breast.
On histology, it is defined by signet ring cells.

How can you grade epithelial ovarian tumours?
Epithelial ovarian tumours can be subclassified as:
- Benign
- Maligant (can metastasise; hase less organised nuclei on histology)
- Boderline (both benign and malignant features)
How can epithelial ovarian tumours be subclassified?
- Serous (70-85% of cases)
- Mucinous
- Endometrioid
- Transitional Cell (aka Brenner Tumour)
- Clear Cell
- Squamous
Name some factors associated with an increased risk for ovarian cancer.
- Age
- Genetics:
- BRCA1/2
- HNPCC
- FHx of ovarian cancer/other cancers
- Reproductive/hormonal factors:
- Nulliparity
- Early menarchy, late menopause
- HRT (very small risk though)
- Medical conditions:
- Endometriosis
- PCOS
- Life style conditions:
- Cigarette smoking (mucinous tumours only)
- Obesity
Name some factors associated with a decreased risk for ovarian cancer.
- Multiparity
- Breast feeding
- COCP use
- Early menopause
- Hyterectomy/Salpingectomy/Oophorectomy
Which genes are associated with an increased risk of ovarian cancer?
- BRCA 1 & 2 (both autosomal dominant)
- Hereditary non-polyposis coloractal cancer (“Lynch Syndrome”)
Distinguish between the benign and malignant form of serous epithelial cell tumours.
Serous tumour are fluid filled, single cysts
Malignant serous cancers are called serous cystadenocarcinoma. On histology one can see Psammoma bodies (see image). It has a worse prognosis than all other types of epithelial ovarian tumours. It typically occurs in postmenopausal women.
The benign form is called serous cystadenoma and typically< affects both ovaries. It tends to occur in pre-menopausal women.
If borderline, follow the patient up for 10 years.
Distinguish between benign and malignant mucinous epithelial cell tumours.
Mucinous tumours are multiloculated mucous filled cysts.
The malignant form is called mucinous cystadenocarcinoma. It is more common in post-menopausal women.
The benign from is called mucinous cystadenoma and is more common in pre-menopausal women. These are usually unilateral.
What is another name for benign endometrioma?
Chocolate Cyst.
Endometrioid tumours can also be malginant (primary ovarian endometrioid carcinoma) in whcih case they spread to the fallopian tubes and the peritoneal cavity.
How can you distinguish a transitional cell (Brenner) tumour on histology?
It is the only solid surface epithelioid tumour.
It is made of transitional cells (usually line the bladder) and are very rare. They are hardly ever malignant.
What are the clinical features that would make you suspect a germ cell tumour?
- Young Woman
- presenting with a large ovarian mass
- that is rapidly growing
List the tumour markers for ovarian cancer.

How would you counsel a woman who is BRCA positive?
- Adivse her that her risk of both breast and ovarian cancer is increased (5% lifetime risk, up to 50% if 2 first degree relatives are affected)
- Advise her on risk reduction (smoking cessation)
- Adivse her that prophylactic BSO (bilateral salpingoophorectomy) is recommended once family is complete
- Offer chemoprevention with the OCP if she doesnt want surgery
Summarise the screening programme for ovarian cancer in the UK.
There is no screening for ovarian cancer.
What are the symptoms of ovarian cancer?
The symptoms are often non-specific. The most common symptoms are:
- Increased abdominal bloating/girth
- Persistent abdo/pelvic pain (also associated with increased likelyhood of ovarian torsion)
- Difficulty eating/feeling full quickly
- Dyspareunia
In any woman over 50: new-onset IBS symptoms
Other symptoms include:
- change in bowel habit
- Urinary symptoms
- Back ache
- Irregular bleeding (PMB) ± fatigue

When should you suspect ovarian cancer?
Suspect ovarian cancer and carry out tests:
- In any woman (esp if >50) with:
- Abdominal distension
- Feeling full/early satiety/appetite loss
- Increased urinary urgency/frequency
- In any woman >50 that has new-onset IBS symptoms
Consider ovarian cancer + testing in women who have the following unexplaind symptoms:
- Weight loss
- Malaise/fatigue
- Change in bowel habit
*
What are the signs of ovarian cancer?
Suspicion of ovarian cancer is raised if on examination you find:
- Ascites
- Adnexal mass might be palpable in slim women
- in premenopausal: 20% of adnexal masses are malignant
- in postmenopausal: 50%
- Adnexal mass might be palpable in slim women
- Pelvic/abdominal mass (NOT caused by fibroids)
- Sister Mary Joseph nodule (umbilical metastasis)

How would you investigate ovarian cancer?
If examination is normal, but symptoms suggestive:
- Measure CA125 concentration
- If >35 IU/mL: arrange TVUSS urgently
- If <35 IU/mL: think of other causes for raised CA125 and safety net (review her regularly and tell her to come back of symptoms more frequent)
If examination is abnormal (e.g. ascites/suspicious mass) :
- Refer to gynaecology and order:
- Initial imaging is TVUSS looks for lump and ascites
- Measure CA125
If USS abnormal:
- CT/MRI for staging and to assess operability
- In some cases, a biopsy of the tumour is indicated
- If indicated, cytology of ascites or pleural effusion
What staging criteria would you use for ovarian cancer?
The FIGO (Federation International de Gynaecologie et d’Obstetrique) staging criteria.
In summary:
- Tumour confined to ovaries
- Tumour confined to pelvis
- Tumour confined to abdominal peritoneum
- Distant metastases (Positive cytology on pleural effusion)
What is the Risk Malignancy Index?
What is the threshold at which they should be referred to a gynaecologist?
The RMI takes into Ultrasound score, menopausal status and CA125 (multiply them with each other to get the RMI).
If the RMI is >250 the woman needs to be reviewed by a gynaecology cancer specialist.
What factors make up the ultrasound component of the RMI?
1 point each for
- Multilocular Cysts
- Solid areas
- Ascites
- Metastases
- Bilateral lesions
Summarise the treatment for ovarian cancer.
Obviously consider the MDT aspect (McMillan nurse, psychologist, GP in addition to gynae servises)
Surgery:
- All patients with ovarian cancer should have surgery for diagnosis, staging and treatment.
- All visible tumour needs to be removed.
- Usually, this means a total abdominal hysterectomy plus bilateral salpingooophorectomy.
- Debulking, i.e. removing some of the surrounding structures (bowel, peritoneal lining), might also be required.
- Lymph nodes may have to be removed.
- However, always keep in mind the woman’s wishes to remain fertile and plan surgery accordingly
Chemotherapy:
- Can be given before (neoadjuvant) or as an adjunct following surgery.
- In ovarian cancer consists of platinum containing compounds and paclitaxel
- Can be intraperitoneal
Follow up patients by clinical examination, CA125.
